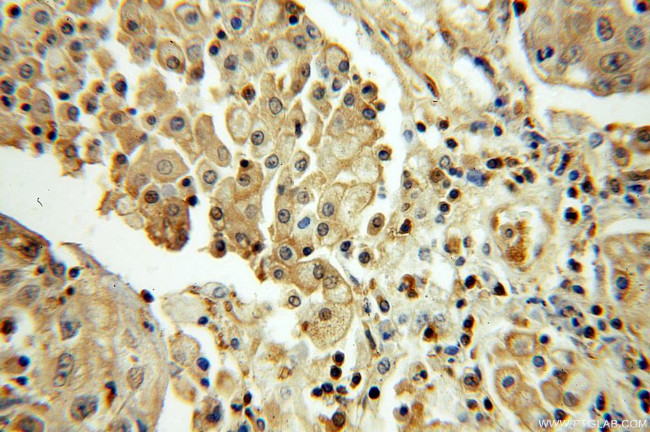
SEPHS1 Antibody in Immunohistochemistry (Paraffin) (IHC (P))

Search
Proteintech
SEPHS1 Polyclonal Antibody
{{$productOrderCtrl.translations['antibody.pdp.commerceCard.promotion.promotions']}}
{{$productOrderCtrl.translations['antibody.pdp.commerceCard.promotion.viewpromo']}}
{{$productOrderCtrl.translations['antibody.pdp.commerceCard.promotion.promocode']}}: {{promo.promoCode}} {{promo.promoTitle}} {{promo.promoDescription}}. {{$productOrderCtrl.translations['antibody.pdp.commerceCard.promotion.learnmore']}}
产品信息
16635-1-AP
种属反应
宿主/亚型
分类
类型
抗原
偶联物
形式
浓度
规格
纯化类型
保存液
内含物
保存条件
运输条件
产品详细信息
Immunogen sequence: MSTRESFNP ESYELDKSFR LTRFTELKGT GCKVPQDVLQ KLLESLQENH FQEDEQFLGA VMPRLGIGMD TCVIPLRHGG LSLVQTTDYI YPIVDDPYMM GRIACANVLS DLYAMGVTEC DNMLMLLGVS NKMTDRERDK VMPLIIQGFK DAAEEAGTSV TGGQTVLNPW IVLGGVATTV CQPNEFIMPD NAVPGDVLVL TKPLGTQVAV AVHQWLDIPE KWNKIKLVVT QEDVELAYQE AMMNMARLNR TAAGLMHTFN AHAATDITGF GILGHAQNLA KQQRNEVSFV IHNLPVLAKM AAVSKACGNM FGLMHGTCPE TSGGLLICLP REQAARFCAE IKSPKYGEGH QAWIIGIVEK GNRTARIIDK PRIIEVAPQV ATQNVNPTPG ATS (1-392 aa encoded by BC000941)
靶标信息
This protein encodes an enzyme that synthesizes selenophosphate from selenide and ATP. Selenophosphate is the selenium donor used to synthesize selenocysteine, which is co-translationally incorporated into selenoproteins at in-frame UGA codons.
仅用于科研。不用于诊断过程。未经明确授权不得转售。
生物信息学
蛋白别名: RP11-24J20.2; selenide; Selenide, water dikinase 1; Selenium donor protein 1; Selenophosphate synthase 1; selenophosphate synthetase 1 +E9; selenophosphate synthetase 1 +E9a; selenophosphate synthetase 1 delta E2; selenophosphate synthetase 1 delta E8; selenophosphate synthetase 1 major; unnamed protein product; Zincore component SEPHS1
基因别名: 1110046B24Rik; AA589574; AI505014; AW111620; SELD; SEPHS1; SPS; SPS1
UniProt ID: (Human) P49903, (Mouse) Q8BH69
Entrez Gene ID: (Human) 22929, (Rat) 291314, (Mouse) 109079